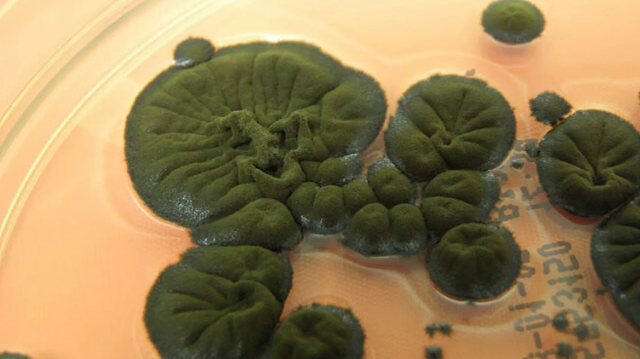
Sopp i Tsjernobyl ser ut til å kunne «spise» stråling

Forskning
Sopp i Tsjernobyl ser ut til å kunne «spise» stråling

Hønseegg kan i mange tilfelle erstatte forsøksdyr

Dansk forsker er hjernen bak IT-milliardærs forsøk på å skape designerbabyer

Norsk Polarinstitutt investerer 175 millioner i beltevogner

Aarhus universitet avviser flere søkere fra Kina, Iran og Russland – frykter spionasje
%2520(002).jpg)
Ny nasjonal forskningssatsing skal gjøre norske veier og jernbane tryggere

Kommentar
Gjør deg klar for ny teknologi-revolusjon
Tormod Haugstad - Kommentator

Debatt
Byggenæringen må engasjere seg mer i forskning

– Har for første gang klart å finne DNA svevende i lufta

Alt du lurte på om Cern

Deler ut 175 millioner til å kommersialisere forskning

Birger Steen til Norsar

DNA-et i sedimentene kan være hundretusener år gamle. Gir innblikk i forhistorisk klima

Debatt
«Mørk oksygen» – fra sensasjon til tabbe
